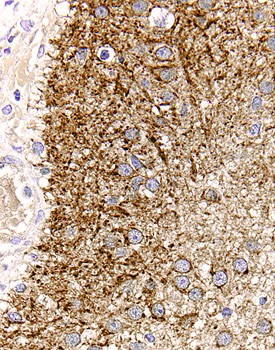
TGF-a antibody in Human Astrocytoma by Immunohistochemistry (IHC-P).

Human TGF-alpha Antibody
R&D Systems, part of Bio-Techne | Catalog # AF-239-NA


Key Product Details
Species Reactivity
Validated:
Cited:
Applications
Validated:
Cited:
Label
Antibody Source
Product Specifications
Immunogen
Val40-Ala89
Accession # P01135
Specificity
Clonality
Host
Isotype
Endotoxin Level
Scientific Data Images for Human TGF-alpha Antibody
Cell Proliferation Induced by TGF‑ alpha and Neutralization by Human TGF‑ alpha Antibody.
Recombinant Human TGF-a (Catalog # 239-A) stimulates proliferation in the Balb/3T3 mouse embryonic fibroblast cell line in a dose-dependent manner (orange line). Proliferation elicited by Recombinant Human TGF-a (3 ng/mL) is neutralized (green line) by increasing concentrations of Goat Anti-Human TGF-a Antigen Affinity-purified Polyclonal Antibody (Catalog # AF-239-NA). The ND50 is typically 0.15-0.75 µg/mL.TGF-alpha in Human Astrocytoma.
TGF-a was detected in immersion fixed paraffin-embedded sections of human astrocytoma using 15 µg/mL Goat Anti-Human TGF-a Antigen Affinity-purified Polyclonal Antibody (Catalog # AF-239-NA) overnight at 4 °C. Before incubation with the primary antibody tissue was subjected to heat-induced epitope retrieval using Antigen Retrieval Reagent-Basic (Catalog # CTS013). Tissue was stained with the Anti-Goat HRP-DAB Cell & Tissue Staining Kit (brown; Catalog # CTS008) and counterstained with hematoxylin (blue). View our protocol for Chromogenic IHC Staining of Paraffin-embedded Tissue Sections.TGF-alpha in Human Astrocytoma.
TGF-a was detected in immersion fixed paraffin-embedded sections of human astrocytoma using Goat Anti-Human TGF-a Antigen Affinity-purified Polyclonal Antibody (Catalog # AF-239-NA) at 15 µg/mL overnight at 4 °C. Tissue was stained using the Anti-Goat HRP-DAB Cell & Tissue Staining Kit (brown; Catalog # CTS008) and counterstained with hematoxylin (blue). Lower panel shows a lack of labeling if primary antibodies are omitted and tissue is stained only with secondary antibody followed by incubation with detection reagents. View our protocol for Chromogenic IHC Staining of Paraffin-embedded Tissue Sections.Applications for Human TGF-alpha Antibody
Immunohistochemistry
Sample: Immersion fixed paraffin-embedded sections of human astrocytoma subjected to Antigen Retrieval Reagent-Basic (Catalog # CTS013)
Western Blot
Sample: Recombinant Human TGF-alpha (Catalog # 239-A)
Neutralization
Human TGF-alpha Sandwich Immunoassay
Formulation, Preparation, and Storage
Purification
Reconstitution
Formulation
Shipping
Stability & Storage
- 12 months from date of receipt, -20 to -70 °C as supplied.
- 1 month, 2 to 8 °C under sterile conditions after reconstitution.
- 6 months, -20 to -70 °C under sterile conditions after reconstitution.
Background: TGF-alpha
TGF-alpha was originally isolated from the conditioned media of oncogenically transformed cells as an EGF-like bioactivity. TGF-alpha is a member of the EGF family of cytokines that are synthesized as transmembrane precursors and are characterized by the presence of one or several EGF structural units in their extracellular domain. The soluble forms of these cytokines are released from the transmembrane protein by proteolytic cleavage. Membrane-bound proTGF-alpha is biologically active and seems to play a role in mediation of cell-cell adhesion and in juxtacrine stimulation of adjacent cells. Expression of TGF-alpha is widespread in tumors and transformed cells. TGF-alpha is also expressed in normal tissues during embryogenesis and in adult tissues, including pituitary, brain, keratinocytes and macrophages. Mature TGF-alpha shows approximately 93% amino acid sequence identity with mouse or rat TGF-alpha and is not species specific in its biological effects.
TGF-alpha binds to the EGF receptor and activates the receptor tyrosine kinase. Accordingly, TGF-alpha shows a similar potency to EGF as a mitogen for fibroblasts and as an inducer of epithelial development in vivo. TGF-alpha is reportedly more potent than EGF as an angiogenic factor in vivo and as a stimulator for keratinocyte migration. The EGF receptor gene represents the cellular homologue of the avian v-erb-B oncogene.
Long Name
Alternate Names
Entrez Gene IDs
Gene Symbol
UniProt
Additional TGF-alpha Products
Product Documents for Human TGF-alpha Antibody
Product Specific Notices for Human TGF-alpha Antibody
For research use only